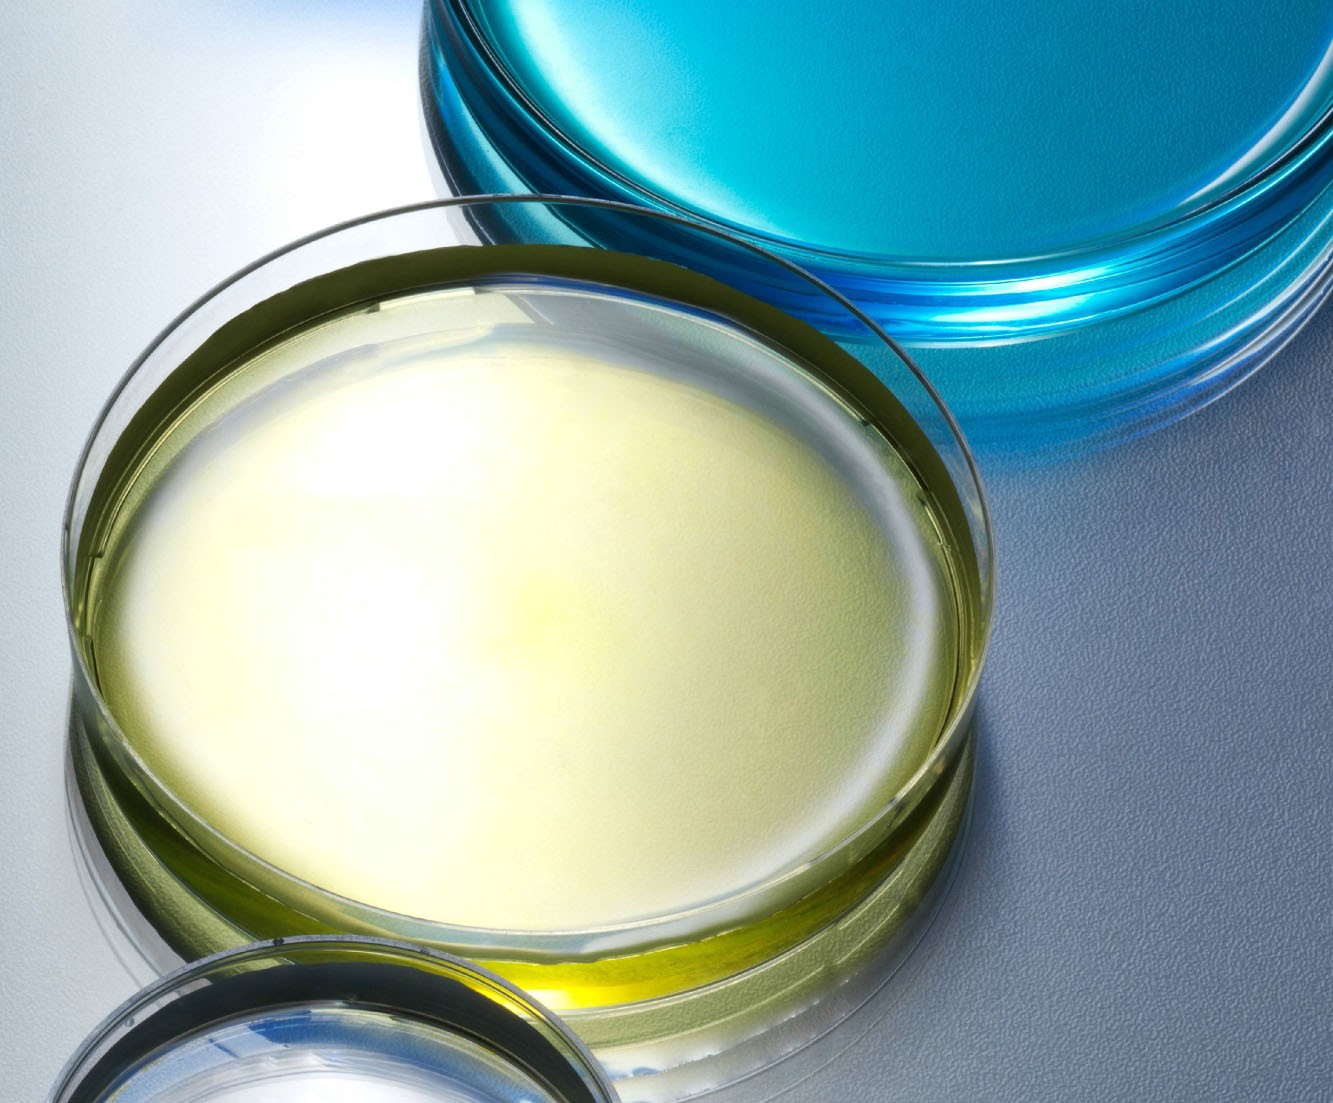

От хорошей жизни
Знакомый знакомого привил ребенка, и тот умер. Вакцины вызывают аутизм. Болезни, против которых направлены прививки, не опасны. «Вокруг света» выяснил, насколько состоятельны аргументы противников вакцинации

Представьте, что каждый год все люди в Москве умирают. А за сто лет погибает в 3,5 раза больше народу, чем сегодня живет в России. Причем этот мир покидают в основном дети. Такой сценарий кажется невозможным? Зря: все это было реальностью еще в середине прошлого столетия, когда дифтерия ежегодно уносила жизни 13,7 миллиона человек, а оспа за XX век выкосила 300–500 миллионов. Сегодня иммунизация охватывает примерно 85 % населения и от страшных болезней гибнет на порядки меньше людей. Тем не менее некоторые граждане активно выступают против прививок. Их предостережения звучат устрашающе и заставляют многих родителей задуматься об отказе от вакцин. Но если аккуратно и без эмоций разобрать аргументацию антипрививочников, обнаружится множество логических и фактических ошибок.
Аргумент: болезни, от которых нас прививают, хорошо лечатся
В ЧЕМ ОШИБКА: Даже самые эффективные препараты бессильны против многих «прививочных» заболеваний. Пик исследований в области вакцинации пришелся на период, когда на рынок активно выпускались новые мощные антибиотики, побеждавшие, казалось, все неизлечимые болезни. Иллюзия быстро развеялась. От каких-то болезней, против которых есть вакцины, антибиотики помогают, но лечение долгое и не всегда позволяет избежать тяжелых последствий. Но немало «прививочных» заболеваний, например полиомиелит, вызываются вирусами, неподвластными антибиотикам. Эффективные противовирусные препараты до сих пор можно пересчитать по пальцам, не существует их и от полиомиелита. Тем более не получится «подлатать» искореженные вирусом нервы и вернуть подвижность парализованному. А единственный способ спасти невакцинированного от столбняка — экстренно ввести сыворотку крови лошади, привитой столбнячной палочкой. Потому что лучшего лекарства от этого заболевания, чем антитела, у нас нет.
Аргумент: вакцины не защищают на 100 %
В ЧЕМ ОШИБКА: Вакцин, работающих со 100-процентной эффективностью, действительно не существует, но для большинства препаратов этот показатель составляет от 92 до 99 %. Однако у некоторых людей могут быть индивидуальные особенности иммунитета, из-за которых он хуже реагирует на каких-то возбудителей. Поэтому исследователи постоянно дорабатывают состав вакцин, стремясь сделать прививки универсальными. Так что шансов не заболеть у привитого гораздо больше, чем у тех, кто полагается на «природный иммунитет». Эффективность вакцины легко проверить с помощью анализа на напряженность иммунитета. Количество антител к возбудителю в крови покажет, была ли прививка успешной или стоит ее повторить.